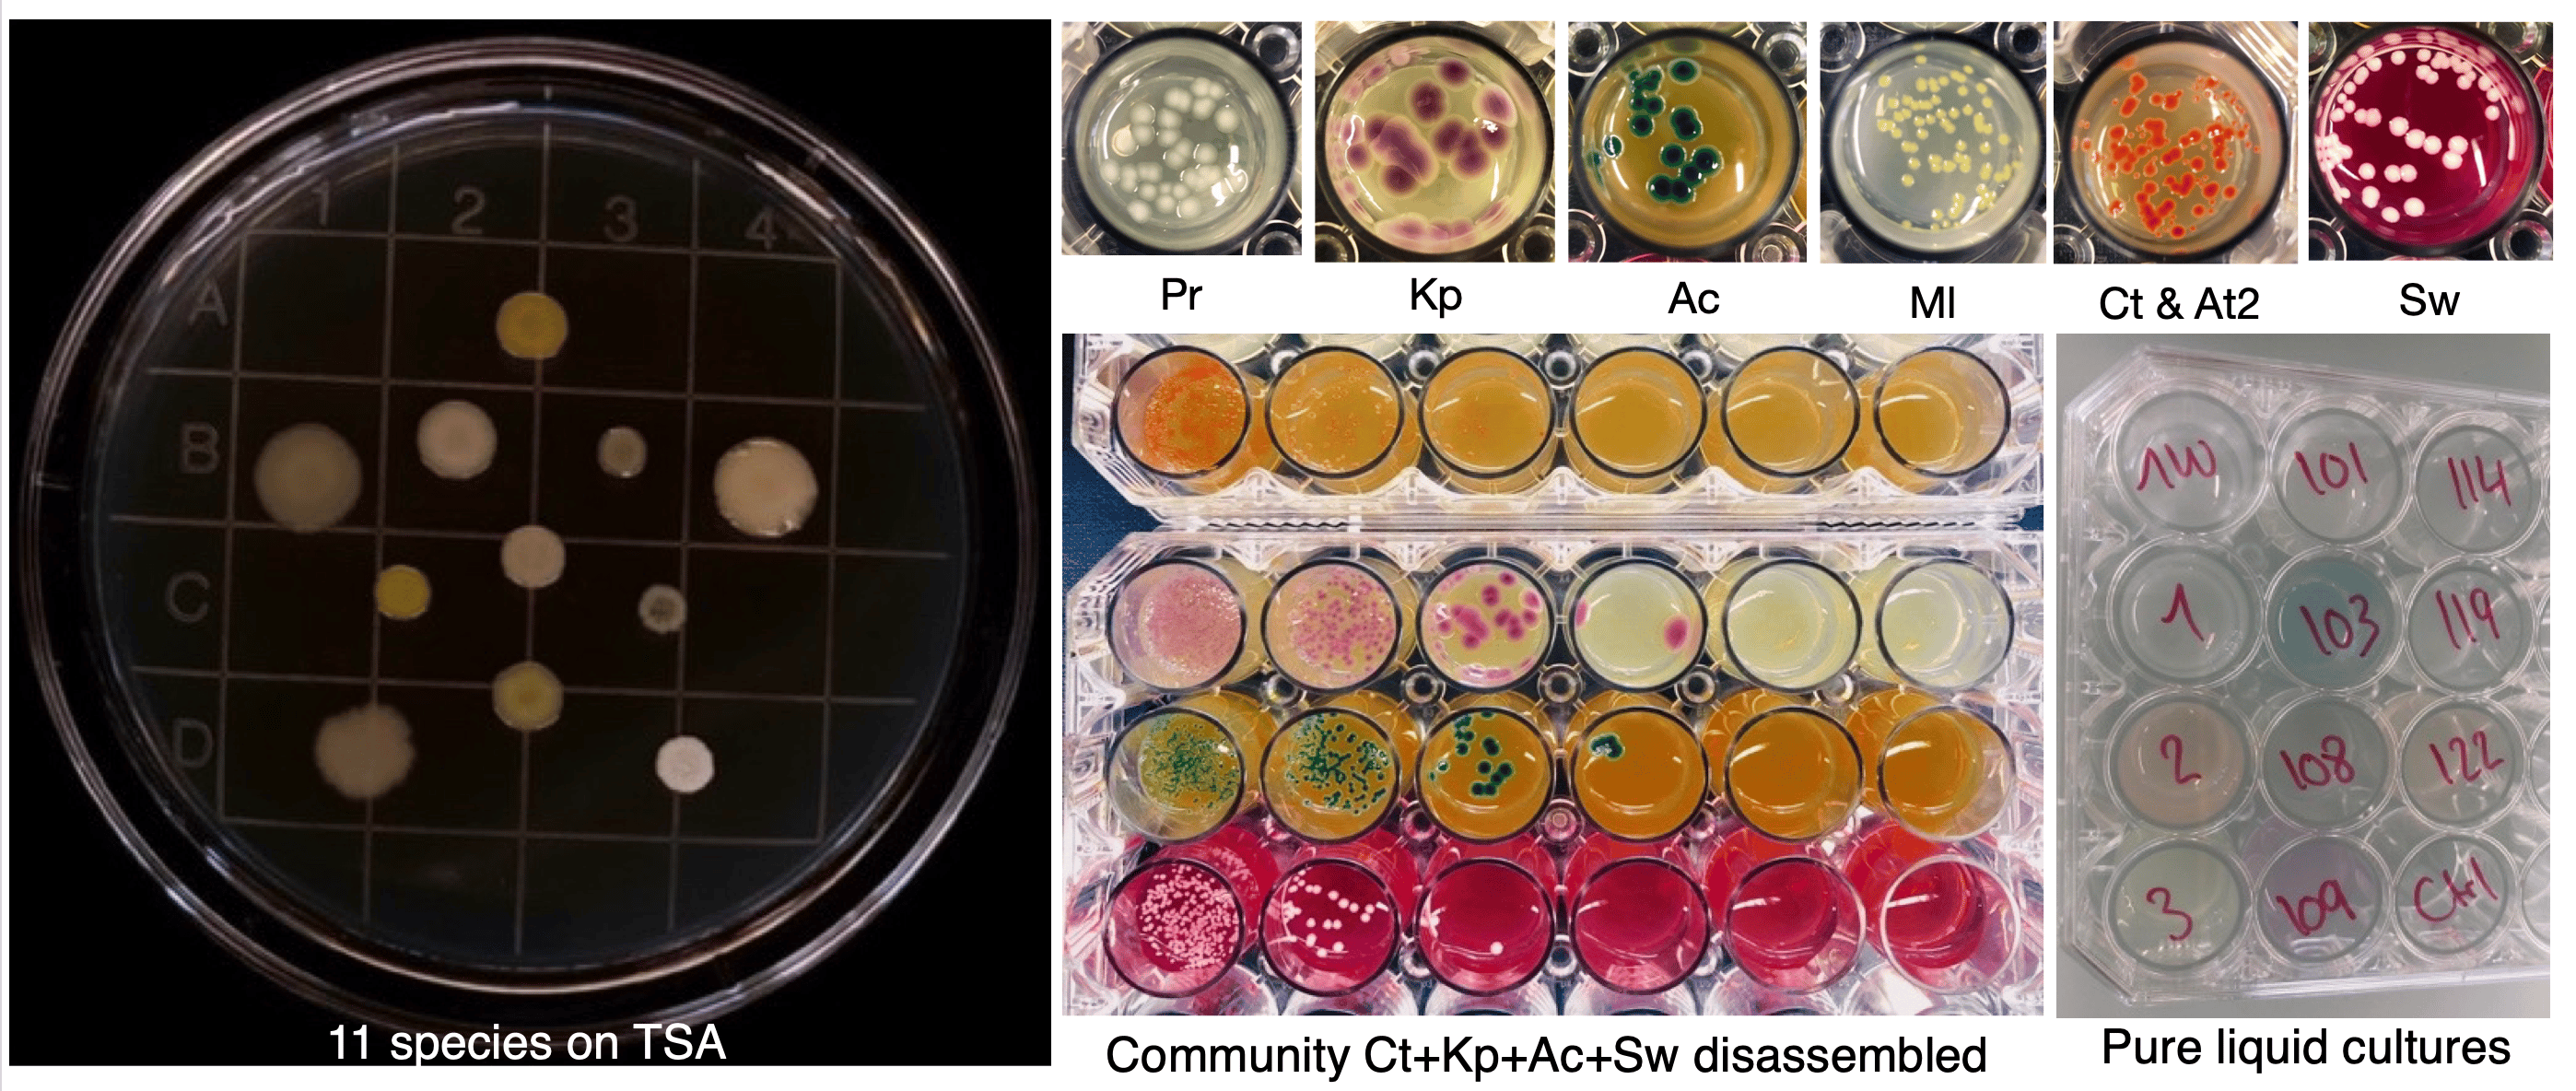

Evolving Solutions: Breeding Bacterial Communities to Battle Pollution
Published in Bioengineering & Biotechnology, Ecology & Evolution, and Microbiology

The Inspiration: From Breeding Dogs to Microbiomes
Our project was inspired by the idea that evolution can be used as an optimization tool. Sara, with her background in the computational sciences and social evolution, wanted to test whether genetic algorithms could work to optimize microbial communities. Björn, an engineer and theoretical biologist was inspired by the idea after I first presented it and offered to write the scripts to help run the experiment. My main interest was with the experiment itself. I was captivated by the brilliance of directed evolution ever since I read this study by a group of chemists that used it to refine the synthesis of didanosine, a pharmaceutical used for HIV treatment. I was eager to perform a similar experiment, not only for the pleasure of doing it, but also for the excitement of seeing the possible results.
With that inspiration in mind, we sought to apply the concept of directed evolution to microbial communities. Rather than focusing on single organisms or molecules, as is typically done, we envisioned applying these principles to entire microbial communities. Our starting question was: if we can breed dogs, why not microbiomes?

We are not the first to test this approach, but our goal was to implement a different selection method inspired by genetic algorithms to experiment with microbial communities in the lab and see whether we could select for less selfish community members that would contribute more to group performance. The concept was ambitious, but it had the potential to make a significant impact in environmental biotechnology by providing a proof of concept solution for bioremediation.
Adapting our ideas to the complexity of microbial ecosystems proved challenging. Although the basic principles of artificial selection remained consistent, designing the experiments from the ground up required extensive work. With few successful precedents to draw from, we spent long hours in deep discussion, relying on our knowledge of evolutionary principles to guide us. These conversations helped us navigate uncharted territory. Björn’s simulations proved particularly helpful, as they helped us to avoid some unnecessary experiments. But we quickly realized that applying the principles of artificial selection to entire microbial communities would likely result in a very complicated experimental setup.
Overcoming Technical Challenges
The main challenge was designing a lab setup that would meet the requirements of the genetic algorithm: The disassembly selection method, the novel approach we proposed, involves repeatedly assembling and disassembling bacterial communities at each round of selection. While assembling communities is straightforward – simply mixing pure cultures of each species in a single tube – disassembling them is much more challenging. Microbial community experiments typically require identifying relative abundances of each species, for which many methods exist, such as 16S amplicon sequencing, qPCR or flow cytometry. But we needed to recover a pure culture of living cells from every mixture so that: (a) each lineage could continue to evolve over the course of the experiment and meet new species combinations in each selection round and (b) we could keep biomass constant at the beginning of every selection round.

We took on the challenge and developed a community disassembly system capable of separating viable cells from each species while also detecting extinctions and contaminations. The system used selective media designed to support the growth of single bacterial species while inhibiting the others. By diluting and plating samples from each community onto each of these individually designed media, we were able to disassemble each of 58 communities over 18 rounds of selection. For some species, we had to tailor the media recipes based on detailed knowledge of their dietary preferences and susceptibilities, a process further complicated by the close phylogenetic relationships between certain species.
It took a full year of intensive lab work, testing hundreds of media recipes. Ironically, this massive effort is represented by just a single supplementary figure (Fig. S8), a reminder of the disconnect between the actual research process and how it is finally presented in a paper. In all honestly, what kept me motivated was how some of the media produced unexpectedly colorful and visually striking colonies that were fun to photograph.
Once the lab challenges were solved, logistical issues emerged. I had to move to Berlin, and Alice and Géraldine joined our team, bringing their exceptional technical skills. Alice mastered both the computational and experimental aspects of the project. After several pilot runs together, she launched the full-scale evolution experiment on her own. At the end of 2019, I moved to Berlin, optimistic about the project’s progress. But then, the unexpected happened…
The Impact of the COVID-19 Pandemic: Adjusting Timelines
As we were running the evolution experiment, the COVID-19 pandemic struck, causing significant disruptions. Like many other research initiatives, we had to pause all laboratory activities due to lockdowns and safety regulations. Unfortunately, we could only complete the experiment up to round 18. We can only speculate now whether extending the experiment might have led to different evolutionary results.
Despite the setback, the pandemic brought unexpected benefits. It forced us to shift much of our work to virtual platforms, which allowed us to communicate frequently even though we were in different cities. This pause, though frustrating, helped us advance our data analysis and explore the data from multiple perspectives. This gave us a clear idea of the follow up experiments that we wanted Géraldine to conduct once restrictions were relaxed.
Pushing Through to the End
Despite the technical and pandemic-related setbacks, our dedication to the project kept us motivated. We faced moments of doubt when experiments failed, or when complicated follow-up experiments yielded negative results: it turns out almost none of the evolved lineages differed much from their ancestors, making the whole disassembly effort unnecessary. Sometimes progress was hindered by external factors, as our personal lives also took unexpected turns. Some team members graduated and moved to non-academic careers, others got married, welcomed new family members (shoutout to Lina and Zafi), or relocated abroad.
Some of our colleagues have questioned our sanity for taking on such a daunting project. In hindsight, our success parallels that of the bacterial species involved in degrading the pollutant: just as several species were needed for the task, we needed our own kind of positive interactions to successfully complete this project. This underscores a frequently over-looked aspect of academia: working with colleagues you like and respect can make a significant difference, especially when the initial excitement fades.
Our project was ambitious, and collaboration was critical to our success. Scientific research is rarely a straightforward journey, and ours was no exception. In the end, our persistence paid off. Our results demonstrated that our artificial selection method can select for microbial communities with enhanced pollution degradation. But perhaps the most valuable takeaway -not only for us but for the research community at large- is how much we have learned about how to do it better next time. It was a true team effort, and the satisfaction of seeing the project come to fruition is immensely rewarding.
Works cited:
1. Arias-Sánchez, F. I., Vessman, B., Haym, A., Alberti, G. & Mitri, S. Artificial selection improves pollutant degradation by bacterial communities. Nature Communications 2024 15:1 15, 1–12 (2024).
2. Birmingham, W. R. et al. Bioretrosynthetic construction of a didanosine biosynthetic pathway. Nature Chemical Biology 2014 10:5 10, 392–399 (2014).
3. Arias-Sánchez, F. I., Vessman, B. & Mitri, S. Artificially selecting microbial communities: If we can breed dogs, why not microbiomes? PLoS Biol 17, (2019).
Follow the Topic
-
Nature Communications
An open access, multidisciplinary journal dedicated to publishing high-quality research in all areas of the biological, health, physical, chemical and Earth sciences.
Related Collections
With Collections, you can get published faster and increase your visibility.
Women's Health
Publishing Model: Hybrid
Deadline: Ongoing
Biosensing
Publishing Model: Hybrid
Deadline: Sep 30, 2026







Please sign in or register for FREE
If you are a registered user on Research Communities by Springer Nature, please sign in